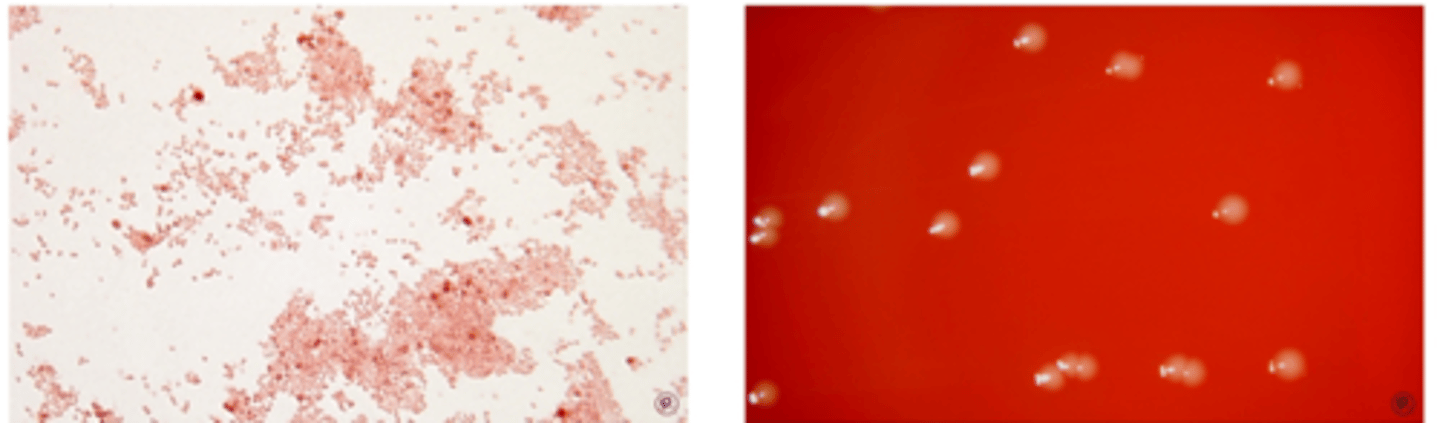
knowt flashcard image
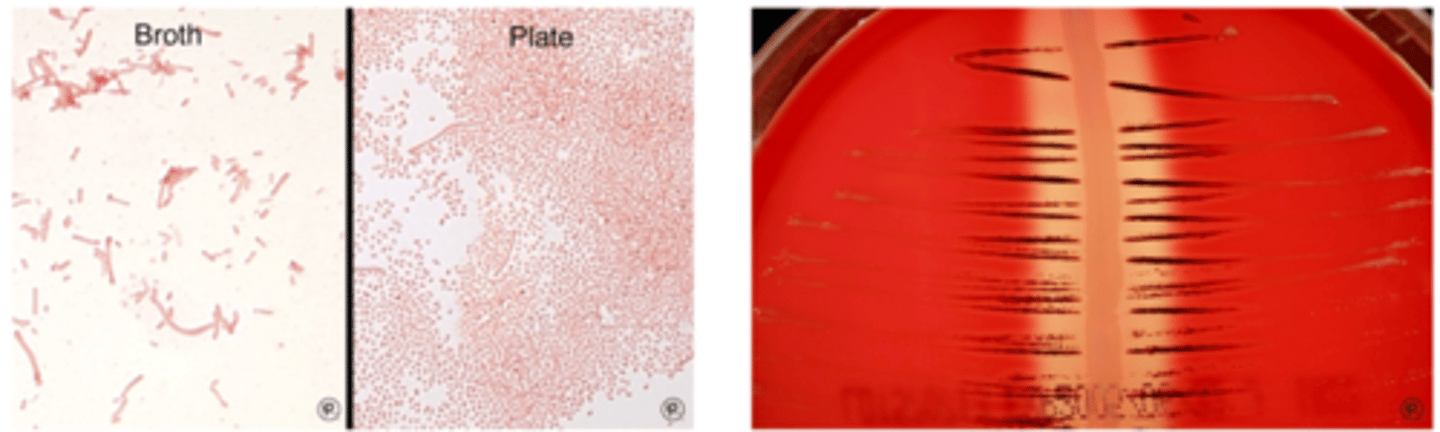
knowt flashcard image

Gram stain and Colony morphology of anaerobes
0.0(0)
Studied by 2 peopleCard Sorting
1/19
There's no tags or description
Looks like no tags are added yet.
Last updated 12:26 AM on 4/13/26
Name | Mastery | Learn | Test | Matching | Spaced | Call with Kai |
|---|
No analytics yet
Send a link to your students to track their progress
20 Terms
1
New cards
Finegoldia magna

2
New cards
Parvimonas micra

3
New cards
Peptostreptococcus anerobius

4
New cards
Veillonella species
5
New cards
Bacteroides fragilis

6
New cards
Bacteroidies ovatus

7
New cards
Bacteroides thetasiotaomicron

8
New cards
Campylobacter ureolyticus

9
New cards
Prevotella melaninogenica
10
New cards
Fusobacterium mortiferum

11
New cards
Fusobacterium necrophorum

12
New cards
Fusobacterium nucleatum

13
New cards
Actinomyces israelii

14
New cards
Eggerthella lenta

15
New cards
Propionibacterium acnes

16
New cards
Clostridium perfringens

17
New cards
Clostridium clostridioforme

18
New cards
Clostridium difficile

19
New cards
Clostridium septicum

20
New cards
Clostridium sporogenes
